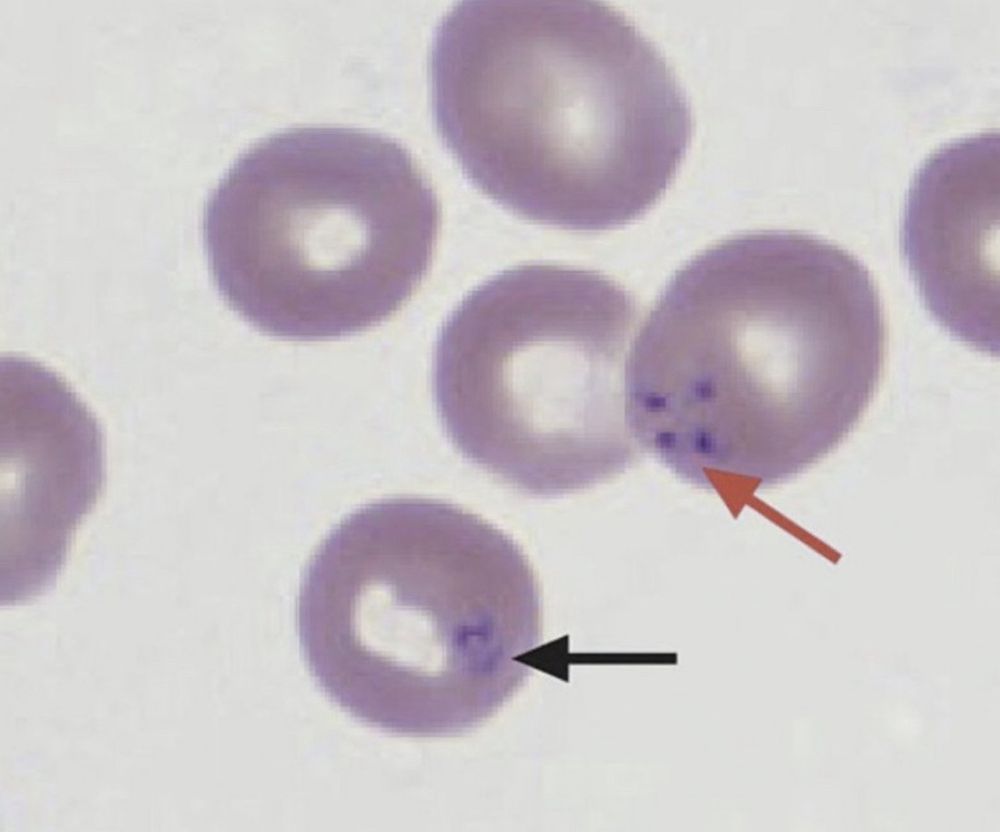

https://buymeacoffee.com/ryanelliott
#medsky #hemesky #hemeonc #lymphoma #pathsky #hemepath #Tcells #cellmarkers #biology #hematology #medicine #pathology #oncology #oncsky #diagnostics #meded

#medsky #hemesky #hemeonc #lymphoma #pathsky #hemepath #Tcells #cellmarkers #biology #hematology #medicine #pathology #oncology #oncsky #diagnostics #meded
Isolated elevation of anticardiolipin IgM does not meet laboratory criteria for antiphospholipid syndrome! According to EULAR 2023 guidelines below. #medsky #IMsky #rheumsky #hemesky #antiphospholipid #thrombosis

Isolated elevation of anticardiolipin IgM does not meet laboratory criteria for antiphospholipid syndrome! According to EULAR 2023 guidelines below. #medsky #IMsky #rheumsky #hemesky #antiphospholipid #thrombosis
Embryo
Hb Gower I = ζ2ε2
Hb Gower II = α2ε2
Hb Portland = ζ2γ2
Fetus
HbF = α2γ2
Adult
HbA = α2β2 ~97%
HbA2 = α2δ2 ~2–3%
HbF <1%
#hemesky #medsky #IMsky #benignheme #hemoglobin #pediatrics

Embryo
Hb Gower I = ζ2ε2
Hb Gower II = α2ε2
Hb Portland = ζ2γ2
Fetus
HbF = α2γ2
Adult
HbA = α2β2 ~97%
HbA2 = α2δ2 ~2–3%
HbF <1%
#hemesky #medsky #IMsky #benignheme #hemoglobin #pediatrics
Humanized protein construct from recombinant DNA (CTLA4 + IgG1 Fc) grown in hamster ovary cells.
Selectively binds to CD80/86 on APCs, inhibiting CD80/86-CD28 costimulatory signal essential for full T-cell activation.
#medsky #IMsky #rheumsky #biologics
(Herrero-Beaumont et al., 2012)

Humanized protein construct from recombinant DNA (CTLA4 + IgG1 Fc) grown in hamster ovary cells.
Selectively binds to CD80/86 on APCs, inhibiting CD80/86-CD28 costimulatory signal essential for full T-cell activation.
#medsky #IMsky #rheumsky #biologics
(Herrero-Beaumont et al., 2012)
Indolent clonal proliferation of mature cytotoxic T cells
- Neutropenia/anemia
- a/w autoimmunity
- CD8+ T cells w/ NK cell markers
- intrasinusoidal bone marrow/spleen/liver path
~50% STAT3 / STAT5b mutation
#hemesky #pathsly #hemepath #IMsky #medsky #leukemia

🫀Class I (Ia, Ib, Ic) - Na+ Channel Blockers
🫀Class II - Beta Blockers
🫀Class III - K+ Channel Blockers
🫀Class IV - Ca2+ Channel Blockers
🫀Class V agents - Other
#medsky #IMsky #internalmedicine #cardiosky

🫀Class I (Ia, Ib, Ic) - Na+ Channel Blockers
🫀Class II - Beta Blockers
🫀Class III - K+ Channel Blockers
🫀Class IV - Ca2+ Channel Blockers
🫀Class V agents - Other
#medsky #IMsky #internalmedicine #cardiosky
Warfarin =🚫II,VII,IX,X
Reverse = Vitamin K, 4-PCC (II,VII, IX, X)
Heparin =🚫II,X
Reverse = Protamine (binds heparin)
Dabigatran =🚫II
Reverse = Idacrucizumab (anti-dabigatran mAb)
Xa inhibitors (Apixaban)
Reverse = Andexanet alfa (Xa decoy & binds drug)
#hemesky #medsky

- Time: ≤ 4 hours
- Cause: cytokines in donor blood
- Prevention: H2 blockers, antipyretics, leukoreduction
- Mgmt: stop infusion, antipyretrics, H2 blockers, meperidine (rigors), r/o other causes, notify blood bank
#hemesky #medsky #IMsky #internalmedicine

- Time: ≤ 4 hours
- Cause: cytokines in donor blood
- Prevention: H2 blockers, antipyretics, leukoreduction
- Mgmt: stop infusion, antipyretrics, H2 blockers, meperidine (rigors), r/o other causes, notify blood bank
#hemesky #medsky #IMsky #internalmedicine
This handy diagram summarizes chemotherapy classes and where they fit according to their mechanism of action ⚙️
#oncsky #hemeonc #hemesky #pharmsky #medsky #IMsky #cancer #chemo
(Falzone et al., 2023. Cell)


Cytoplasm slightly basophilic to cream-coloured
prominent red-purple azurophilic (primary) granules and numerous specific (secondary) granules
nucleoli absent usually
slightly indented nucleus w/ red blue and slightly condensed chromatin
#hemeky #hemepath #pathsky #IMsky

A big thanks to #IMR for this handy comparison table. Good for reference down the road or for someone like myself currently studying for the #InternalMedicine Royal College exam here in Canada.
#cardiosky #medsky #IMsky

A big thanks to #IMR for this handy comparison table. Good for reference down the road or for someone like myself currently studying for the #InternalMedicine Royal College exam here in Canada.
#cardiosky #medsky #IMsky
Infections: 20-40%.
Connective tissue disorders: 20%
Malignancy: 10-20%
Undiagnosed: 20%
Drugs (e.g., phenytoin): rare
#medsky #IMsky #internalmedicine #IDsky #hemeonc #hemesky #oncsky #rheumsky

✨dynamic examination✨
⬆️ preload (squatting) > murmur soft + click late
⬇️ preload (standing) > murmur loud + click early
⬆️ afterload (handgrips) > murmur loud + click late
⬇️ afterload (initial Valsalva) > murmur soft + click early
#cardiosky #medsky #IMsky #emimcc

✨dynamic examination✨
⬆️ preload (squatting) > murmur soft + click late
⬇️ preload (standing) > murmur loud + click early
⬆️ afterload (handgrips) > murmur loud + click late
⬇️ afterload (initial Valsalva) > murmur soft + click early
#cardiosky #medsky #IMsky #emimcc

#medsky #IMsky #internalmedicine #hemesky #hematology #heme #physiology #manualofmedicine

#medsky #IMsky #internalmedicine #hemesky #hematology #heme #physiology #manualofmedicine
#medsky #rheumsky #internalmedicine #medpuns #puns

#medsky #rheumsky #internalmedicine #medpuns #puns
Adult T-cell leukemia/lymphoma (ATL)
A/w HTLV-1 infection, Japan, Caribbean (Jamaica, Trinidad)
Sxs:
LAD, HSM, cytopenias, ⬆️ Ca2+, lytic bone lesions, skin lesions.
Severity ranges from asymptomatic to fulminant.
#hemesky #hemeonc #hemepath #pathsky #medsky #IMsky

Cause: PBG deaminase deficiency leading to accumulation of prophyrins.
Sxs: abdominal pain, neurological disturbances, light sensitivity, skin lesions, red urine.
Ix: peri-attack urine porphyrins
Rx: hemin, pain ctrl, fluids, avoid provoking meds
#hemesky #porphryia

Cause: PBG deaminase deficiency leading to accumulation of prophyrins.
Sxs: abdominal pain, neurological disturbances, light sensitivity, skin lesions, red urine.
Ix: peri-attack urine porphyrins
Rx: hemin, pain ctrl, fluids, avoid provoking meds
#hemesky #porphryia
Ehrlichia chaffeensis
E. ewingii
Lone star tick (A. americanum)
Fevers, rash, myalgias
⬇️platelets+WBC
PB smear: morulae (microcolonies of Ehrlichiae) in cytoplasm of WBCs
E. chaffeensis infects monocytes
E. ewingii infects granulocytes
Rx: Doxycycline
#hemesky #IDsky #medsky

Anaplasma phagocytophilum
Deer tick
Eastern (Ixodes scapularis)
Western (Ixodes pacificus)
Fevers, myalgias
⬇️platelets+WBC
PB smear: morulae in granulocytes
Rx: Doxycycline
Hard to distinguish between erlichiosis, good thing doxy covers both!
#hemesky #IDsky #medsky #IMsky